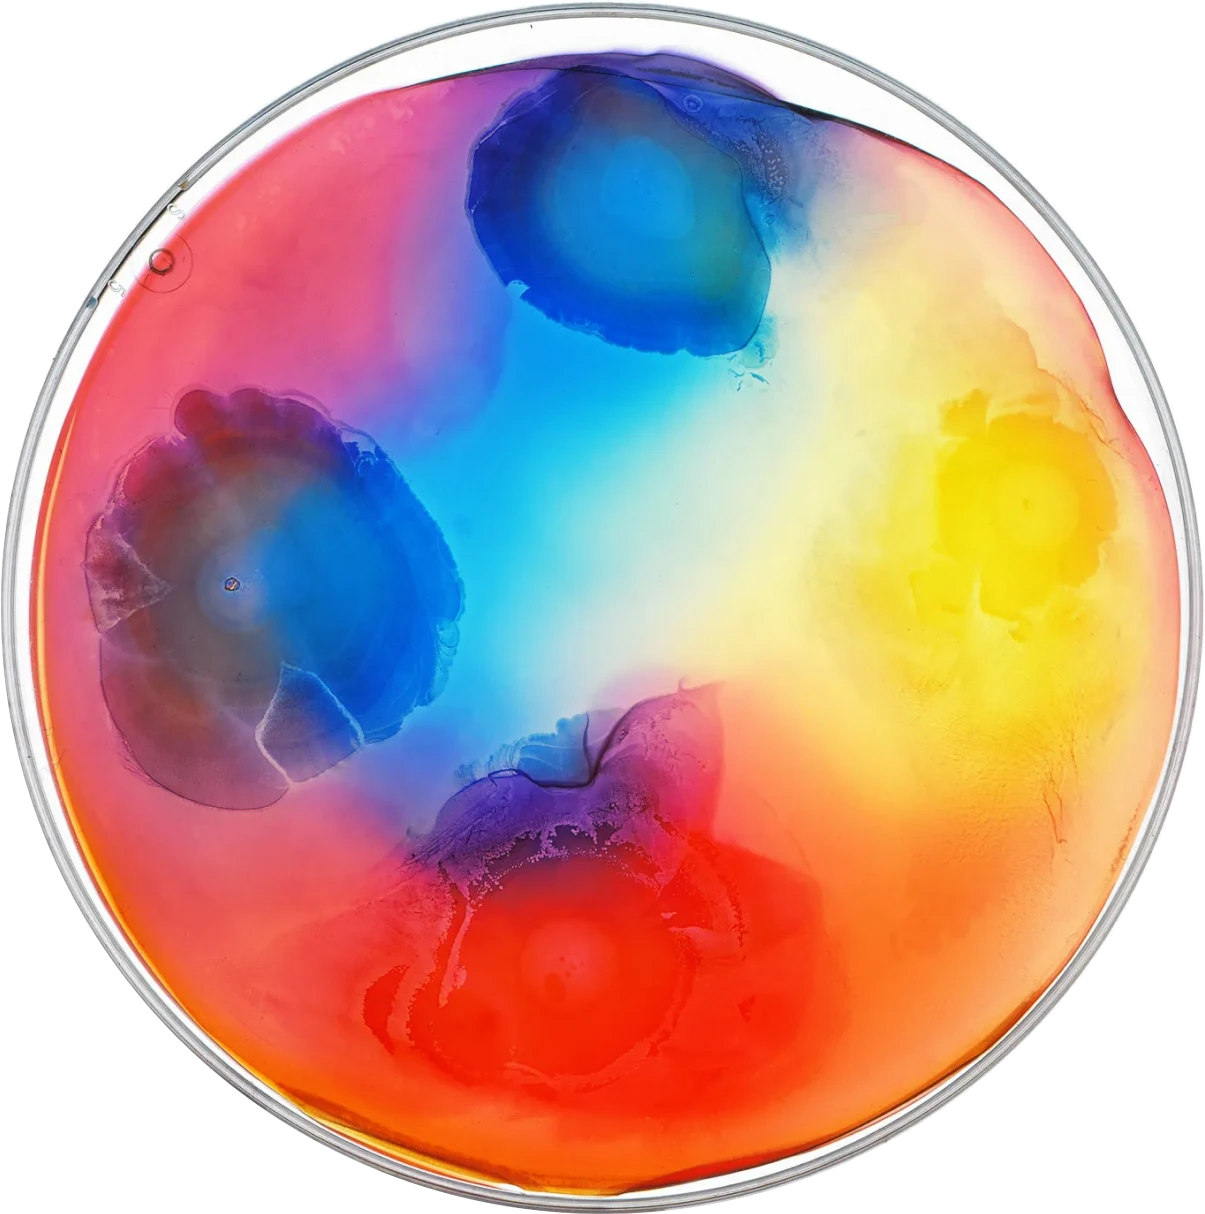

Petri
Beautiful and effective MVP brands and websites for launch-ready biotech companies
About
High impact tools for early-stage growth.
Petri is a cost-effective brand and digital toolkit for early-stage biotech teams. Built to launch fast, designed to grow with you.
Brand
Logo, colors, typography, scientific graphics—strategically created to help you stand out visually to investors, partners, and talent.
Website
A visually engaging, lightweight and easily manageable website that clearly communicates your vision, your value, and your science.
Slide Decks
We design sharp, custom decks for investor pitches, business development, and key meetings. From non-confidential to investor-ready, your story will be clear, cohesive, and easy to follow.
Social Toolkit
We’ll equip you with branded LinkedIn graphics, social banners, and Zoom backgrounds to keep your new look consistent and professional—across every screen and every conversation.
Petri powers your first impression
You’ve got one shot to tell a story that sticks—with investors, partners, and talent. It needs to be sharp, fast, and effective. Petri gives you exactly what you need, nothing you don’t—built to scale when you're ready to grow.
Our process is lean, strategic, and designed to keep you focused on the big decisions while we handle the rest.










The Process
You don’t have six months or hours upon hours for meetings. So, we’ve right-sized our process and timeline to meet the needs and availability of a young company with a small and busy leadership team.

Align & Strategize
Our goal is to understand your moonshot. Through a series of exercises completed asynchronously and in person, ICS will get to know you, your company, and your objectives. This lays the foundation for the project.

Design & Iterate
We create logo, color, and typography concepts to define your brand’s direction. With your input, we refine the designs before you make the final selection.

Build, Test, Launch
We develop your website to be responsive and compatible across browsers and devices. We review it together to make final changes before the big day.
Our work

Agrospheres
Crisp, refined layouts complemented by earthy visuals communicates sustainability, innovation, and accessibility at a glance.
Solu
A clean, modern aesthetic and science-forward structure convey clarity, confidence, and a bold vision for next-generation targeted therapies.
nChroma Bio
Sleek, high-contrast design paired with dynamic visuals communicates precision and innovation, echoing nChroma's work in epigenetic editing and targeted delivery technologies.
Why Petri
Built for biotech. Backed by experience.
Petri is powered by Image Conscious Studios, a branding and web design agency with nearly a decade of hands-on experience helping biotech companies launch, grow, and scale. From stealth mode to IPO, we’ve made the smart calls that help brands stand out and move fast. We focus on what matters most, collaborating with you on the key details that showcase your science and drive your story forward.
Get in touch
Whether you're ready to start tomorrow or just interested to learn more, give us a shout—we love to meet new people and chat about what we do best.